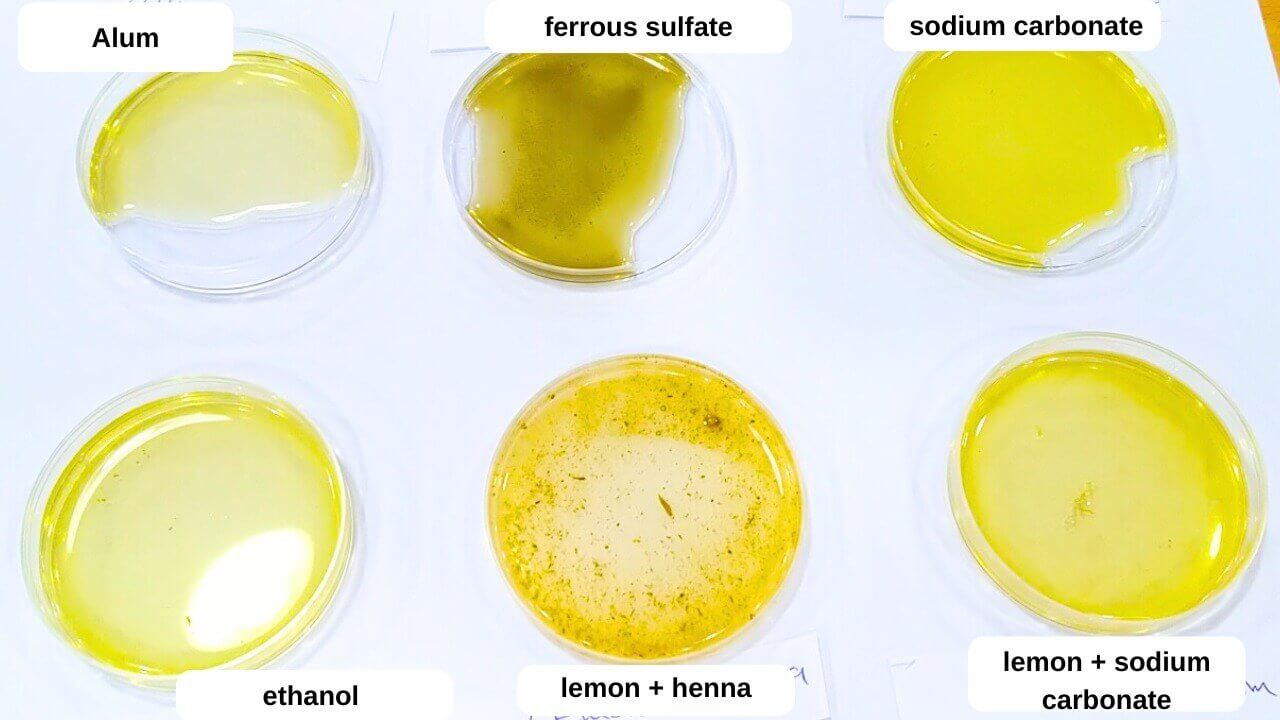

4. BioChromes¶
Introduction¶
For thousands of years, humans have used natural dyes to color fabrics, leather, walls, and even food and cosmetics, making colors an integral part of human culture, identity, and beauty. With the development of industry, these traditional dyes were replaced by synthetic ones that negatively impacted the environment and human health. Today, interest is returning to biochromes—vital colors extracted from plants, fungi, and bacteria—as a sustainable alternative that restores the balance between beauty and nature. This week's mission aims to explore the world of natural dyes and their properties, and understand how they can be employed in innovative ways not only in fashion but also in art, design, and contemporary biomaterials, in a journey that combines heritage and technology.
Research¶
The Concept of Biochromes and Natural Pigments
Biochromes are naturally occurring pigments chemically produced in living organisms such as plants, animals, and fungi. These pigments are biodegradable, non-toxic, and hypoallergenic, making them an environmentally friendly option compared to synthetic dyes.
Classification of Natural Pigments¶
- Natural pigments are divided into several main categories based on their chemical composition:
- Anthocyanins: Pigments that give colors ranging from red to blue, found in berries and grapes.
- Carotenoids: Pigments that give orange and yellow colors, found in carrots and tomatoes.
- Flavonoids: Pigments that give colors ranging from yellow to blue, found in apples and onions.
- Chlorophyll: The green pigment found in plants, responsible for photosynthesis.
- Betalains: Pigments that give red and yellow colors, found in beets.
History of the Use of Natural Colors¶
Humans have used natural dyes since ancient times to color fabrics, leather, art, and cosmetics. In the Middle Ages, dyes extracted from plants and animals were widely used, but with the Industrial Revolution in the 19th century, they were replaced by synthetic dyes due to their low cost and ease of production. However, environmental and health concerns have led to a resurgence of interest in natural dyes in the modern era.
Environmental Advantages of Natural vs. Synthetic Dyes¶
- Natural dyes have several environmental advantages over synthetic dyes:
- Biodegradable: They do not pollute the environment upon disposal.
- Non-toxic: They are safe for human use and the environment.
- Renewable Sources: They are extracted from plants and animals.
However, natural dyes face some challenges, such as color fastness, reaction to light, and washing, which require the use of stabilizers (mordants) to improve color fastness.
Inspiration¶
The local environment plays a pivotal role in inspiring natural colors. In Jordan and Palestine, nature abounds with rich sources of plant dyes that can be used in sustainable design. These include wild plants such as wild hibiscus, fenugreek, and wild rosemary, as well as agricultural waste such as onion peels, pomegranate seeds, and date peels, providing colors ranging from red, yellow, orange, and purple.
The region's cultural heritage provides an additional source of inspiration, as natural dyes have been used for centuries to color traditional fabrics and arts and crafts, linking natural beauty with cultural identity.
Today, the region is witnessing several local initiatives and projects that are sustainably reviving these traditional techniques:
Safi Crafts - From the Heart of Jordan: Re-cultivating the historic indigo plant to extract blue, in collaboration with UNESCO.
Palestinian Traditional Industries: Using natural dyes in hand embroidery and traditional textiles, such as red from silkworms and blue from the indigo plant.
By studying these local sources and existing projects, traditional knowledge and modern techniques can be combined to produce colorful fabrics that reflect the history and spirit of the region, while simultaneously highlighting the value of sustainability and innovation.
References¶
Synthetic vs. Natural Dyes - Did You Know...
Medicinal Plants Used in Jordan for dying
This week was full of fun, exploration, and a lots of colors and wonder. It included beautiful transitions between the lab and nature and vice versa, with an abundance of unique information and experiences that added great passion and enthusiasm.
We started our week with a table full of cheerful colors on different types of fabrics.
After enjoying the beauty and brightness of the colors, we began to learn about the types of fibers and the materials that would be added to them during the dyeing process.
We then moved to the dyeing process, where we began preparing the fibers for dyeing by scouring to mordanting with all materials that we need during this process like different modant types.
The next day, we embarked on a short and enjoyable trip into nature, where we discovered a picturesque and enchanting location. We wandered around and searched for plant species that can be used to extract natural dyes.
After this trip, it was our turn to explore the world of natural dyes ourselves.
Ingredients & Recipes¶
ingredients necessary, to be found in the list below:
Tools:¶
-
Pots
-
Beakers and Container
-
Hob
-
Scale
-
Spoons & Silicone Spatula
-
Sieve
-
Clamps
-
Labels & Marker
-
Threads
Fibers:¶
-
Plant Fibres: Cotton Fabric, linnen, Threads.
-
Animal Fibres: Wool.
Additives:¶
-
Natural dye stuff (flowers, leaves, roots...etc)
-
Mordant: potassium aluminum sulfate
-
Modifiers: Lemon, Vinegar, sodium carbonate, Ferrous sulphate,potassium aluminum sulfate, henna, ethanol,
Solvents:¶
-
Water
-
Ethanol
Process and workflow¶
Textiles & fibers preparing¶
1- WEIGHT OF FIBRES (WoF).
The weight of fiber (WOF) is an essential factor, as it determines exactly how much alum and washing soda to add. Weigh the fibers separately, animal and plant, as the preparation process between them is slightly different.
2-Scouring.
I did a scouring for plant fibers,So I boiled a water, then added a tablespoon of washing soda. I placed the fibers in the boiling water and let them for nearly one hour.
In our lecture we did scouring for plant fibers.
For animal fibers we just clean it with one or two spoons of soab and warm water, depends of weight of fiber as we said before.
3-Mordanting
I rinsed the fibers after scouring and added it to boiling wter with 10% of its weight alum for another hour, then I rinsed them with water
DYE BATHS.¶
- Dittrichia viscosa
Dittrichia viscosa is a highly branching perennial common throughout the Mediterranean Basin. It has long, narrow leaves that are pointed at both ends and have teeth along the edges and glandular hairs on the surfaces. One plant can produce many yellow flower heads each with as many as 16 ray florets and 44 disc florets.
you can read more abou it Here
I was lucky to find the plant in two stages, and I made two dye baths by boiling each seedling individually in water for an hour.
After boiling for one houre I let it in water for another one houre, then Iplaced the fabric in dye bath, I placed one with shibori.
Also I weperimented modifires like sodium carbonate, ethanol, lemon ferrous sulphat and alum.
I let all in dyes for one night.

and her we go :)
the next picture shows the dyes from the first stage which I found for Dittrichia vuscosa

and here you can find the colors that I got from the second stage of Dittrichia viscosa that I found during our trip

- hoary mullein, chestnuts, pomegranate, tanners summac
With the same previous steps I made dyes with all these ingredients and plants parts and got gourges colors.
- Hoary mullein
Verbascum pulverulentum, the hoary mullein, is a species of flowering plant in the family Scrophulariaceae.It is native to western, central and southern Europe north to England (where its main range is in East Anglia) and southern Wales. It has been introduced to Austria, Madeira, and Washington state in the USA. It is a specialist on coastal shingle, and so is preadapted to human-influenced habitats such as old quarries and gravel pits, road verges, railway embankments, and similar disturbed stony ground.
you can read more abou it Here
- Chestnuts
Actually It's well known that chestnuts aren't always available in Jordan, especially at this time of year. However, since I work in design and experimentation with biomaterials, I collect any materials that I find might be useful. Last winter, I collected chestnut shells and experimented with dyeing them.
to prepare chestnuts dye bath, just add 200 ml of water into the pot, when the water start boiling add the dried and ground shells and stir, keep it boiling for 35 min then, let it for a while befor start using.
- pomegranate
I also collect pomegranate and dried it to use it in biomaterials so I used it to try different dyes.

to prepare dried pomegrante dye bath, just add 150 ml of water into the pot, when the water start boiling add the pomegrante dried and ground peels and stir, keep it boiling for 20 min then, let it for a while befor start using.
- Tanners summaq
I found this plant while I was walking during our trip, according to PLANTNET App this is a Tanners summaq plant.
Rhus coriaria, commonly called Sicilian sumac,tanner's sumach, or elm-leaved sumach, is a deciduous shrub to small tree in the cashew family Anacardiaceae. It is native to southern Europe and western Asia. The dried fruits are used as a spice, particularly in combination with other spices in the mixture called za'atar.
you can read more abou it Here
to prepare tanners summac dye bath, just add 150 ml of water into the pot, when the water start boiling add the plant and stir, keep it boiling for 20 min then, let it for a while befor start using.
INKS¶
I experimented preparing the inks using the dye bath that we prepared during the week in the lab from turmeric, onions, and cabbage, and added gum arabic, and the result was wonderful colors.
The first one was turmeric water dye bath and I added arabic gum so this shiny yellow appeard.
The second one was cabbage, I did 2 experiments on it the first experiment is just cabbage water dye bath with arabic gum to get this nice purple color.
The cabbage second experiment was the same dye bath with adding ethanol to it and then I added arabic gum, so i got this amazing dark blue.
The last one is the onion water dye bath with adding arabic gum to get this golden brownish color.
Pigments¶
To prepare the Lake pigments using a mordant I used the remaining chestnut dye bath, which was approximately 200 ml, to which I added 15 grams of alum. Then I gradually added 8 grams of sodium carbonate dissolved in hot water and waited an hour, after which I started strained the mixtur using cotton sheet.
the resulted pigment color was light beige :
during this period I tried to make an oil colors using the pigment that we did in the lab, so I added a tea spoon of corn oil to a pinch of pigment and I got this amazing color.
RESULTS:¶
In the foloowing catalaog you can find all dyes results with all fibers and mordant and modifiers details:
Bellow apictures taken during the processes (boards photoshoot):